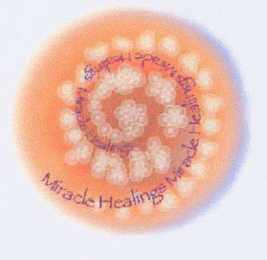
MIRACLE HEALINGS

Trademark Attorney / Law Firm
Bruce W. McRoy – Trademark Portfolio
Bruce W. McRoy has filed 30 trademarks with the United States Patent and Trademark Office (USPTO). Filing records span from 1994 to 2011, covering 6 years of intellectual property practice. Of these filings, 5 are currently registered. The portfolio covers 18 Nice Classification classes, with the highest concentration in Class 41 (Education & Entertainment, 5 filings) and Class 42 (Computer & Scientific, 4 filings).
Showing of trademarks Trademarks

Practice Areas by Trademark Class
Bruce W. McRoy's trademark practice covers 18 Nice Classification classes, representing the range of industries and goods/services handled in their USPTO filings.
Education; providing of training; entertainment; sporting and cultural activities
Scientific and technological services; industrial analysis and research services
Insurance; financial affairs; monetary affairs; real estate affairs
Scientific, nautical, surveying, photographic, cinematographic, optical apparatus and instruments
Games and playthings; gymnastic and sporting articles; decorations for Christmas trees
Bleaching preparations and other substances for laundry use; cleaning, polishing, scouring
Paper and cardboard; printed matter; bookbinding material; photographs; stationery
Common metals and their alloys; metal building materials; transportable buildings of metal
Frequently Asked Questions
How many trademark applications has Bruce W. McRoy filed?
Bruce W. McRoy has filed 30 trademark applications with the United States Patent and Trademark Office (USPTO). Of these, 5 registered, 14 abandoned, 11 cancelled.
What trademark classes does Bruce W. McRoy specialize in?
Bruce W. McRoy has filed trademarks across 18 Nice Classification classes. The most common practice areas include Class 41 (Education & Entertainment), Class 42 (Computer & Scientific), Class 36 (Insurance & Financial), Class 9 (Computers & Electronics), Class 28 (Toys & Sporting Goods). Class 41 covers education; providing of training; entertainment; sporting and cultural activities.
How long has Bruce W. McRoy been filing trademarks?
Bruce W. McRoy's trademark filing history with the USPTO spans from 1994 to 2011, covering 17 years of trademark practice. During this period, Bruce W. McRoy has handled 30 trademark applications.
What is Bruce W. McRoy's trademark registration success rate?
Bruce W. McRoy has a 17% trademark registration rate, with 5 out of 30 resolved applications resulting in successful registration. Currently, 0 applications are pending review.
